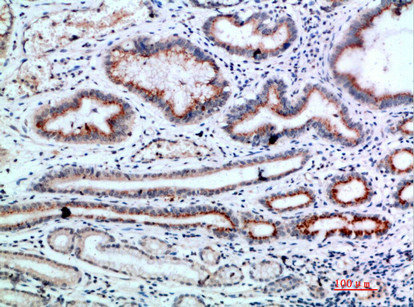
L1CAM Antibody

You have no items in your shopping cart.
Search results for: 'L1CAM (CD171)'
- Featured

Mouse
15.63-1000 pg/mL
7 pg/mL
48 T, 96 T - Featured

Human
0.16-10 ng/mL
0.055 ng/mL
96 T, 48 T - Featured

- Featured
Featured
Human
93.75-6000pg/mL
56.25 pg/mL
48 T, 96 T - Featured
L1CAM Rabbit Polyclonal Antibody [orb315797]Featured
IF, IHC, WB
Human, Mouse, Rat, Zebrafish
Rabbit
Polyclonal
Unconjugated
30 μl, 100 μl, 200 μl, 50 μl - Featured
CD171/L1CAM Rabbit Polyclonal Antibody [orb13325]Featured
ELISA, FC
Human
Bovine, Canine, Equine, Gallus, Mouse, Porcine, Rabbit, Rat
Rabbit
Polyclonal
Unconjugated
50 μl, 100 μl, 200 μl

![Anti-CD171 [L1-14.10]](/images/pub/media/catalog/product/NewWebsite/35/orb758890_1.png)
![Anti-CD171 [L1-14.10]](/images/pub/media/catalog/product/NewWebsite/35/orb758891_1.png)

